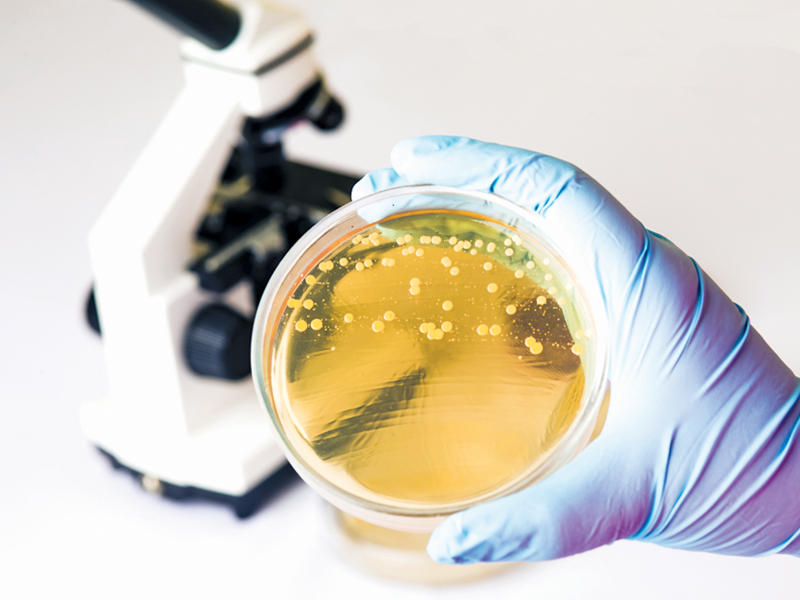

خطوات بسيطة لمحاربة داء المبيضات (candida)
تشير المبيضات البيضاء إلى خميرة تعيش عموماً في الفم والمهبل والجهاز الهضمي
ولا تسبب مشاكل حين تحافظ على مستويات طبيعية. لكنها قد تصبح مسؤولة عن أعراض النفخة، والطفح الجلدي، وعدوى الخميرة، والإرهاق وغيرها من المشاكل، حين تنمو بوتيرة مفرطة نتيجة مجموعة متنوعة من العوامل، مثل سوء الحمية الغذائية، والإجهاد المرتبط بالرياضة، واختلال الوظيفة الهضمية.
ولا تسبب مشاكل حين تحافظ على مستويات طبيعية. لكنها قد تصبح مسؤولة عن أعراض النفخة، والطفح الجلدي، وعدوى الخميرة، والإرهاق وغيرها من المشاكل، حين تنمو بوتيرة مفرطة نتيجة مجموعة متنوعة من العوامل، مثل سوء الحمية الغذائية، والإجهاد المرتبط بالرياضة، واختلال الوظيفة الهضمية.
للاحتماء من فرط نمو المبيضات، يجب أن تتجنب تناول الفاكهة الغنية بالسكر والكربوهيدرات ومشتقات الحليب والسكر بجميع أشكاله، بما في ذلك العسل أو شراب القيقب، مقابل التركيز على استهلاك اللحوم غير الدهنية والأسماك والدواجن والخضراوات غير النشوية والدهون الصحية.وفيما يلي خطوات لمحاربة هذا الداء:
1- زيت جوز الهند
يكون زيت جوز الهند غنياً بأحماض الكابريليك والكابريك واللوريك. تتمتع هذه الأحماض الدهنية بخصائص مضادة للفطريات وتساهم في كبح نمو المبيضات ومسببات أمراض أخرى. يكون حمض اللوريك الموجود في جوز الهند فاعلاً جداً أيضاً ضد قروح الفم، كما يسمح بالوقاية من عدوى المبيضات في الفم، أو مرض القلاع.اطبخي الهليون واللوز المفروم والبصل والثوم على نار خفيفة في زيت جوز الهند، أو اخلطي زيت جوز الهند الذي يحتوي على دهون ثلاثية متوسطة السلسلة مع بضع قطرات من زيت النعناع الأساسي وغرغري فمك بالخليط للقضاء على مسببات الأمراض.
2- الكركم
يحتوي الكركم على عنصر الكركمين المضاد للالتهابات والفطريات، ما يعني أنه يكبح نمو المبيضات ويحمي من عدوى الخميرة. كشفت إحدى الدراسات أن الكركمين يعوق قدرة الخميرة على مهاجمة خلايا الفم، ومن المعروف أن الكركمين يتماشى أيضاً مع مفعول دواء الفلوكونازول المضاد للفطريات.قلِّبي براعم بروكسل المبشورة مع الفليفلة الحمراء والبصل والزنجبيل المفروم والكركم والفلفل الأسود، أو اخلطي اللوبياء في مسحوق الكاري والفلفل الأسود وزيت جوز الهند المذوّب، وحمّري الخليط إلى أن يصبح مقرمشاً.3- الثوم
يكون الثوم غنياً بعنصر الأليسين الذي ينشأ عند سحق الفصوص أو فرمها، وقد تبيّن أنه يعوق تكاثر الفطريات والجراثيم. كشفت الدراسات أن الأليسين يستطيع أن يمنع فرط نمو المبيضات، حتى أنه قد يضعف قدرة المبيضات على مهاجمة الخلايا التي تحدّ الفم. بما أن السخونة قد تضرّ بالأليسين، فمن الأفضل أن يُؤكَل الثوم نيئاً لحصد أكبر المنافع منه.اسحقي فصوص الثوم الكاملة واخلطيها مع زيت جوز الهند وإكليل الجبل أو الزعتر المفروم، واسكبي هذا الخليط بدل الزبدة فوق الخضراوات المطبوخة. أو افرمي فصوص الثوم بنعومة واخلطيها مع خل التفاح وزيت الزيتون والزعتر المفروم للحصول على صلصة سهلة للسلطات.4- الزنجبيل
يحتوي الزنجبيل على عناصر مضادة للفطريات مثل الجنجيرول والشاغيلول. تكشف دراسات عدة أن الزنجبيل يتمتع بمفعول قوي على مستوى مكافحة الميكروبات، وقد يكبح نمو المبيضات ومسببات أمراض أخرى. في إحدى الدراسات، تبيّن أن الكريم المضاد للفطريات الذي يحتوي على زنجبيل مضاف كان أكثر فاعلية في تخفيف عدوى الخميرة من الكريم الذي يخلو من الزنجبيل.افرمي الزنجبيل الطازج بنعومة واخلطيه مع معجون الميزو وخل التفاح وزيت السمسم للحصول على صلصة قشدية، أو سخني جذر الزنجبيل المبشور مع «نودلز» الكوسا لتحضير مرق الخضار، ثم اسكبيه فوق شرائح البصل الأخضر وبراعم الفاصوليا والحبق المفروم وفليفلة الجالابينو المقطعة.5- الكيمتشي
يكون الكيمتشي (طبق من الملفوف المخمّر) غنياً بمجموعة متنوعة من المحفزات الحيوية لحماية الأمعاء من مسببات الأمراض. تكشف الدراسات أن المحفزات الحيوية تخفف التهابات الأمعاء وتحمي من فرط نمو خميرة المبيضات، حتى أنها قد تخفف أعراض المبيضات. بما أن الكيمتشي يخلو من مشتقات الحليب ويحتوي عموماً على الثوم والزنجبيل، سيكون خياراً مثالياً ضمن الحمية الغذائية المضادة للمبيضات. تتعدد الأغذية الأخرى الغنية بالمحفزات الحيوية والخالية من مشتقات الحليب، منها كفير جوز الهند والميزو والتمبيه والملفوف المخلل.اخلطي ورق السبانخ المبشور مع الكيمتشي وبذور السمسم السوداء والطماطم المفرومة لتحضير سلطة سهلة، أو حضّري نودلز باللفت عبر تغطيسه في المرق إلى أن يصبح طرياً ثم ضعي الكيمتشي فوقه.6- خل التفاح
يُستعمل خل التفاح منذ فترة طويلة للاحتماء من عدوى الخميرة والقلاع. تكشف الدراسات أنه يتمتع بخصائص مضادة للميكروبات، حتى أنه قد يكون أكثر فاعلية من دواء النيستاتين المضاد للفطريات للوقاية من فرط نمو المبيضات في الفم.اخلطي خل التفاح مع الزنجبيل المفروم والثوم المهروس والكركم، واتركي الخليط طوال الليل قبل تصفيته للحصول على خل قوي المفعول. أو اخلطي الملفوف الأحمر والأخضر بعد فرمه مع البصل الأحمر والكزبرة المفرومة وفلفل سيرانو المفروم وخل التفاح وزيت الزيتون لتحضير سلطة الكرنب سريعاً.7- الكرنب
يكون الكرنب وغيره من الخضراوات الورقية غنياً بالألياف التي تغذي الجراثيم المعوية المفيدة، وقد تحمي هذه المنتجات من فرط نمو المبيضات. ينتمي الكرنب أيضاً إلى فئة الخضراوات الصليبية، ما يعني أنه غني بعناصر تقلص نمو المبيضات على ما يبدو. تتعدد أنواع الخضراوات غير النشوية التي تتماشى مع الحمية المضادة للمبيضات، منها السبانخ، والأنديف، والجرجير، وبراعم بروكسل، والملفوف، والبروكلي، والكرفس، واللوبياء، والخيار، والباذنجان، والبصل والكوسا.قلّبي الكرنب المفروم مع الفطر المقطع في زيت جوز الهند، ثم اسكبي الثوم المفروم بنعومة فوقه. أو اخلطي مكعبات الأنديف والكراث في زيت الزيتون واشوي الخليط إلى أن يصبح طرياً.
الزنجبيل يحتوي على عناصر مضادة للفطريات مثل الجنجيرول والشاغيلول